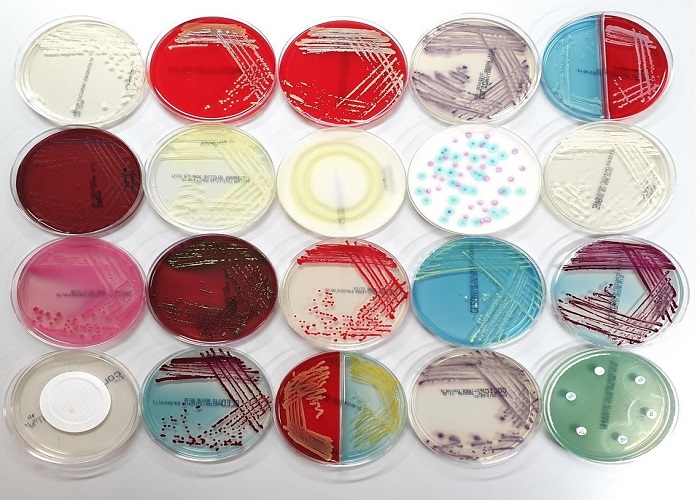
مقایسه انواع محیط کشت

مقایسه انواع محیط کشت
مقایسه انواع محیط کشت یکی از مهم ترین موضوعاتی است که در آزمایشگاه های میکروبی، تحقیقاتی و تشخیصی مورد توجه قرار میگیرد. محیط های کشت به عنوان ابزار اصلی رشد و بررسی میکروارگانیسم ها شناخته میشوند و انتخاب صحیح آن ها میتواند تأثیر مستقیمی بر دقت نتایج آزمایش، سرعت رشد باکتری ها و کیفیت تحلیل های میکروبی داشته باشد. به همین دلیل آشنایی با انواع محیط کشت و کاربرد هرکدام برای متخصصان آزمایشگاهی اهمیت بسیار زیادی دارد.
در بسیاری از آزمایش ها تنها رشد میکروارگانیسم ها کافی نیست؛ بلکه شناسایی دقیق، تفکیک گونه ها و بررسی ویژگیهای بیوشیمیایی نیز اهمیت دارد. به همین دلیل شناخت تفاوت ها و انجام مقایسه انواع محیط کشت به کارشناسان آزمایشگاه کمک میکند تا متناسب با نوع آزمایش، بهترین محیط را انتخاب کرده و از بروز خطا در نتایج جلوگیری کنند.
انتخاب نادرست محیط کشت آماده میتواند باعث رشد ناقص میکروارگانیسمها یا حتی عدم شناسایی صحیح آن ها شود. بنابراین هنگام انتخاب محیط مناسب باید به نوع آزمایش، میکروارگانیسم هدف، شرایط دمایی، دقت مورد نیاز و تجهیزات مورد استفاده توجه ویژه داشت. در چنین شرایطی بررسی دقیق ویژگی ها و انجام مقایسه انواع محیط کشت نقش مهمی در افزایش کیفیت و دقت نتایج آزمایشگاهی خواهد داشت.
در آزمایشگاه های میکروبی، محیط های کشت در دسته های مختلفی مانند عمومی، انتخابی، تمایزی و تخصصی قرار میگیرند. هرکدام از این محیط ها برای هدف خاصی طراحی شدهاند و کاربرد های متفاوتی دارند. آشنایی با این دستهبندی ها و شناخت مزایا و محدودیت های هرکدام، روند انجام آزمایش ها را دقیق تر و حرفهای تر میکند. در این مقاله تلاش کرده ایم با ارائه یک مقایسه انواع محیط کشت، ویژگی ها، مزایا، معایب و کاربرد های هر گروه را بررسی کنیم تا بتوانید مناسب ترین محیط کشت را برای آزمایش مورد نظر خود انتخاب کنید و کیفیت کار در آزمایشگاه را افزایش دهید.
مقایسه انواع محیط کشت
محیط های کشت بر اساس هدف آزمایش، نوع میکروارگانیسم و شرایط رشد به دسته های مختلفی تقسیم می شوند. هر یک از این محیط ها دارای ترکیبات و ویژگی های مشخصی هستند که آن ها را برای آزمایش خاصی مناسب می کند. به همین دلیل آشنایی با انواع محیط کشت و شناخت ساختار محیط کشت میکروبی و حتی محیط کشت پایه برای انتخاب صحیح در آزمایشگاه اهمیت زیادی دارد.
در مقایسه انواع محیط کشت، این محیط ها را می توان بر اساس کاربرد و ساختار به گروه های مختلفی تقسیم کرد. از نظر فیزیکی، محیط ها به محیط کشت مایع، محیط کشت نیمه جامد و محیط کشت جامد تقسیم می شوند که هر کدام برای هدف مشخصی مانند تکثیر، نگهداری یا جداسازی میکروارگانیسم ها کاربرد دارند. همچنین برخی محیط ها به عنوان محیط کشت پایه شناخته می شوند و مبنای تهیه بسیاری از محیط های اختصاصی و میکروبی محسوب می شوند.
از نظر کاربرد تخصصی نیز، محیط های کشت در دسته های عمومی، انتخابی، تمایزی و تخصصی قرار می گیرند. محیط های عمومی برای رشد گسترده میکروارگانیسم ها استفاده می شوند، در حالی که محیط های انتخابی تنها به گروه خاصی از باکتری ها اجازه رشد می دهند. محیط های تمایزی امکان تشخیص و تفکیک باکتری ها را فراهم می کنند و محیط های تخصصی برای رشد ارگانیسم های خاص طراحی شده اند.
شناخت دقیق تفاوت ها، مزایا و محدودیت های هر گروه باعث می شود کارشناسان آزمایشگاه بتوانند بر اساس نوع آزمایش، نوع نمونه و هدف بررسی، مناسب ترین گزینه را انتخاب کنند. انجام یک مقایسه دقیق بین انواع محیط کشت نه تنها دقت نتایج را افزایش می دهد، بلکه از خطا های آزمایشگاهی و هزینه های اضافی نیز جلوگیری می کند.
۱. محیط کشت عمومی
محیط کشت های عمومی (General Purpose Media) از رایج ترین محیط ها در آزمایشگاه های میکروبی هستند و برای رشد طیف وسیعی از باکتری ها و میکروارگانیسم ها استفاده میشوند. محیط هایی مانند نوترینت آگار و Tryptic Soy Agar (TSA) ترکیبات غذایی پایه مورد نیاز برای رشد میکروب ها را فراهم میکنند و به همین دلیل برای کشت اولیه نمونه ها بسیار کاربردی هستند. این محیط ها معمولاً زمانی استفاده میشوند که هدف اصلی، رشد کلی میکروارگانیسمها و بررسی اولیه نمونه باشد نه شناسایی دقیق آنها.
در بسیاری از آزمایشگاه ها، از محیط های کشت عمومی برای شمارش باکتری ها، بررسی آلودگی میکروبی و آماده سازی کشت های اولیه استفاده میشود. همچنین این محیط ها در آزمایشگاه های آموزشی و تحقیقاتی به دلیل سهولت استفاده و هزینه مناسب بسیار پرکاربرد هستند و پایه بسیاری از آزمایش های میکروبی را تشکیل میدهند.
مزایا:
یکی از مهم ترین مزایای محیط کشت عمومی، توانایی رشد طیف گسترده ای از میکروارگانیسم ها است. این محیط ها ساده، در دسترس و مقرون به صرفه هستند و برای آزمایش های روزمره آزمایشگاهی انتخاب مناسبی محسوب میشوند. همچنین استفاده از آن ها نیاز به شرایط پیچیده ندارد و در اکثر آزمایشگاه ها قابل تهیه و استفاده است.
معایب:
با وجود کاربرد گسترده، محیط های کشت عمومی برای شناسایی دقیق میکروارگانیسم های خاص مناسب نیستند. این محیط ها بیشتر برای رشد کلی باکتری ها کاربرد دارند و برای تفکیک گونه ها یا تشخیص ویژگی های خاص میکروبی باید از محیط های انتخابی یا تمایزی استفاده شود.
۲. محیط کشت انتخابی
محیط های کشت انتخابی به گونه ای طراحی میشوند که شرایط رشد را فقط برای گروه مشخصی از میکروارگانیسم ها فراهم کنند و هم زمان از رشد سایر میکروب ها جلوگیری نمایند. این ویژگی باعث میشود که در نمونه های ترکیبی یا آلوده، بتوان باکتری یا قارچ هدف را با دقت بیشتری جداسازی و بررسی کرد. بهعنوان مثال، محیط مک کانکی آگار با داشتن ترکیبات خاص، رشد باکتری های گرم مثبت را محدود کرده و امکان رشد باکتری های گرم منفی مانند اشریشیاکلی را فراهم میکند.
این نوع محیط ها معمولاً حاوی مواد مهارکننده، آنتیبیوتیک ها یا ترکیبات شیمیایی ویژه هستند که رشد میکروارگانیسم های ناخواسته را کاهش میدهند. به همین دلیل در آزمایش های تشخیصی پزشکی، کنترل کیفیت مواد غذایی و بررسی آلودگی های میکروبی بسیار پرکاربرد هستند. استفاده از محیط کشت انتخابی کمک میکند تا نتایج آزمایش سریع تر و دقیق تر به دست آید و روند شناسایی میکروارگانیسم هدف ساده تر شود.
مزایا:
شناسایی و جداسازی باکتریها یا قارچ های خاص
افزایش دقت در آزمایش های تشخیصی و تخصصی
مناسب برای بررسی نمونههای دارای چند نوع میکروارگانیسم
معایب:
کاربرد محدود برای گروه مشخصی از میکروارگانیسمها
مناسب نبودن برای کشت عمومی یا بررسیهای اولیه
نیاز به انتخاب دقیق بر اساس هدف آزمایش
۳. محیط کشت تمایزی
محیط های کشت تمایزی (Differential Media) به گونه ای طراحی شدهاند که بتوانند تفاوت های بیوشیمیایی و متابولیکی میان میکروارگانیسم ها را به صورت قابل مشاهده نشان دهند. این محیط ها علاوه بر فراهم کردن شرایط رشد، دارای ترکیبات خاصی هستند که در صورت فعالیت متابولیکی متفاوت باکتری ها یا قارچ ها، تغییراتی مانند تغییر رنگ، ایجاد رسوب، تولید گاز یا همولیز در محیط ایجاد میشود. همین ویژگی باعث میشود بتوان گونه های مختلف میکروبی را از یکدیگر تفکیک و شناسایی کرد.
برای مثال، محیط بلاد آگار یکی از شناخته شده ترین محیط های تمایزی است که بر اساس نوع همولیز (تجزیه گلبول های قرمز) توسط باکتری ها، امکان تشخیص و تفکیک آن ها را فراهم میکند. برخی باکتری ها باعث همولیز کامل، برخی همولیز ناقص و برخی هیچگونه همولیزی ایجاد نمیکنند و این تفاوت به راحتی در محیط قابل مشاهده است. چنین ویژگی هایی باعث میشود محیط های تمایزی در آزمایش های تشخیصی پزشکی، میکروب شناسی و کنترل کیفیت بسیار کاربردی باشند.
این محیط ها معمولا در شرایطی استفاده میشوند که تنها رشد میکروارگانیسم کافی نیست و نیاز به شناسایی دقیق تر و بررسی ویژگی های بیوشیمیایی وجود دارد. به همین دلیل در کنار محیط های عمومی یا انتخابی، نقش مهمی در آزمایشگاه های تخصصی ایفا میکنند.
مزایا:
تفکیک دقیق تر باکتری ها و میکروارگانیسم ها
نمایش تغییرات بیوشیمیایی، رنگی یا متابولیکی به صورت قابل مشاهده
کمک به شناسایی سریع تر و دقیق تر در آزمایش های تشخیصی
معایب:
نیاز به بررسی و تفسیر دقیق نتایج توسط کاربر متخصص
هزینه بالاتر نسبت به محیط های عمومی
در برخی موارد نیاز به شرایط نگهداری و کنترل دقیقتر برای مشاهده نتایج صحیح
۴. محیط های کشت خاص
محیط های کشت خاص به گونه ای طراحی شده اند که شرایط بهینه برای رشد میکروارگانیسم های ویژه یا ارگانیسم هایی با نیاز های خاص فراهم شود. این محیط ها ممکن است شامل ترکیبات منحصر به فرد، مواد مغذی اختصاصی یا شرایط فیزیکی ویژه باشند که فقط گروه مشخصی از میکروارگانیسم ها میتوانند در آن رشد کنند. برای مثال، محیط SDA (Sabouraud Dextrose Agar) به طور خاص برای کشت قارچ ها و مخمر ها استفاده میشود و شرایطی مانند pH و نوع قند موجود در محیط را برای رشد این ارگانیسم ها بهینه میکند.
این محیط ها در آزمایشگاه های تخصصی زیست فناوری، داروسازی، مطالعات سلولی و تحقیقاتی که نیاز به شناسایی دقیق یا کشت ارگانیسم های خاص دارند، کاربرد گستردهای دارند. علاوه بر این، محیط های خاص میتوانند به کاهش رشد میکروارگانیسم های غیر هدف کمک کنند و در نتیجه دقت نتایج آزمایش را افزایش دهند.
مزایا:
شرایط بهینه و دقیق برای رشد میکروارگانیسمهای ویژه
افزایش دقت در آزمایشهای تخصصی و تحقیقاتی
کاهش تداخل ناشی از میکروبهای غیر هدف
معایب:
هزینه بالاتر نسبت به محیطهای عمومی یا انتخابی
محدود بودن کاربرد و نیاز به تخصص برای استفاده صحیح
اغلب نیاز به تجهیزات یا نگهداری ویژه برای دستیابی به نتایج دقیق
جدول مقایسه انواع محیط کشت
| نوع محیط کشت | ویژگیها | مزایا | معایب | مثالها |
|---|---|---|---|---|
| عمومی | رشد طیف گسترده میکروارگانیسمها | ساده و مقرونبهصرفه | شناسایی دقیق محدود | نوترینت آگار، TSA |
| انتخابی | رشد گروه خاصی از باکتریها | تفکیک دقیقتر | کاربرد محدود | مک کانکی آگار |
| تمایزی | تفکیک بر اساس ویژگی بیوشیمیایی | شناسایی دقیق | نیاز به بررسی دقیق | بلاد آگار، EMB |
| خاص | مناسب برای ارگانیسمهای ویژه | دقت بالا در آزمایشهای خاص | هزینه بیشتر | SDA |
انتخاب صحیح محیط کشت تأثیر مستقیمی بر کیفیت نتایج آزمایشگاهی دارد. در فرآیند مقایسه انواع محیط کشت باید به نوع میکروارگانیسم، هدف آزمایش و شرایط آزمایشگاهی توجه شود. محیط های عمومی برای بررسی اولیه مناسب هستند، در حالی که محیط های انتخابی و تمایزی برای شناسایی دقیقتر استفاده میشوند. در آزمایش های تخصصی نیز محیط های خاص کاربرد دارند و انتخاب آنها باید با دقت انجام شود. با شناخت کامل ویژگی ها و کاربرد های هر محیط کشت، میتوان بهترین گزینه را برای هر آزمایش انتخاب کرد و دقت و ایمنی کار در آزمایشگاه را افزایش داد.
سوالات متداول
۱.محیط کشت پایه چیست و چه کاربردی دارد؟
محیط کشت پایه (Base Media) یا محیط عمومی، محیطی است که مواد مغذی اصلی برای رشد اکثر میکروارگانیسمها را فراهم میکند و برای کشت اولیه و بررسی رشد عمومی مناسب است.
۲.در مقایسه انواع محیط کشت چه زمانی باید از محیط کشت انتخابی استفاده کرد؟
زمانی که هدف شناسایی یا تفکیک یک گروه خاص از میکروبهاست، مثلا باکتری های گرم منفی، استفاده از محیطهای انتخابی مانند مک کانکی آگار ضروری است.
۳.مزیت اصلی محیط های تمایزی چیست؟
محیط های تمایزی امکان تشخیص تفاوت های متابولیکی و بیوشیمیایی بین میکروارگانیسم ها را فراهم میکنند و باعث شناسایی دقیقتر باکتری ها میشوند.
۴.آیا همه محیط های کشت میتوانند به صورت جامد، نیمهجامد یا مایع تهیه شوند؟
بله، بسته به هدف آزمایش، محیطهای کشت میتوانند جامد (با آگار)، نیمهجامد یا مایع (Broth) باشند تا شرایط رشد و بررسی میکروارگانیسمها بهینه شود.
۵.محیط های خاص چه تفاوتی با محیط های عمومی دارند؟
محیط های خاص برای ارگانیسم های ویژه و شرایط رشد تخصصی طراحی شدهاند، در حالی که محیط های عمومی برای طیف وسیعی از میکروبها کاربرد دارند و شرایط استاندارد برای رشد را فراهم میکنند.
محصولات مشابه:
پلیت یکبار مصرف ۸ سانت







